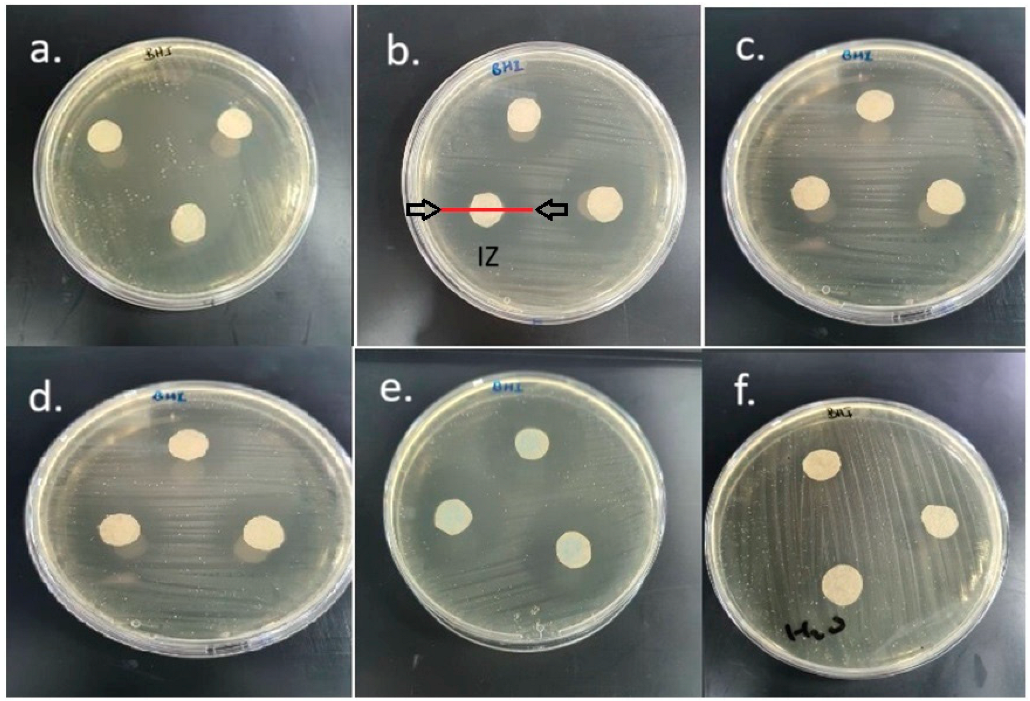
Applsci 15 03704 g003 Applsci 15 03704 g003

In Vitro Evaluation of the Antimicrobial Properties of Natural Toothpastes Containing Silver, Citrus, and Cranberry Extracts Against Oral Pathogenic Microorganisms
Abstract
1. Introduction
2. Materials and Methods
2.1. Preparation of the Natural Toothpaste
2.2. Preparation of the Developed Natural Antimicrobial Toothpastes
2.3. Evaluation of the Antimicrobial Properties of the Developed Toothpastes
- Test product: The filter paper discs were impregnated with 25 µL of the product being tested, which was diluted 50% with water. The discs were placed on the surface of pre-inoculated agar plates. The same procedure was repeated for all microorganisms.
- Negative test: The filter papers were impregnated with 25 µL of sterile water. The discs were aseptically placed on the surface of pre-inoculated agar plates. The same procedure was repeated for all the tested microorganisms.
- Each test product was compared with a negative control product, which did not contain an antimicrobial agent, and with a positive control product, which was a commercially available synthetic toothpaste (Instant Whitening Blue Toothpaste, Frezyderm SA, Athens, Greece), whose antimicrobial action was proven. The composition of this toothpaste is: deionized water, blue covasorb, hydrated silica, Cymenol, 0.32% w/w sodium fluoride (1450 ppmF).
2.4. Statistical Analysis
3. Results
4. Discussion
5. Conclusions
Author Contributions
Funding
Institutional Review Board Statement
Informed Consent Statement
Data Availability Statement
Acknowledgments
Conflicts of Interest
References
- Liu, J.K. Natural products in cosmetics. Nat. Prod. Bioprospect. 2022, 12, 40. [Google Scholar] [CrossRef] [PubMed]
- Cervellon, M.C.; Carey, L. Consumers’ perceptions of ‘green’: Why and how consumers use eco-fashion and green beauty products. Crit. Stud. Fashion Beauty 2011, 2, 117–138. [Google Scholar] [CrossRef]
- Amberg, N.; Fogarassy, C. Green consumer behavior in the cosmetics market. Resources 2019, 8, 137. [Google Scholar] [CrossRef]
- Banakar, M.; Fernandes, G.V.O.; Etemad-Moghadam, S.; Frankenberger, R.; Pourhajibagher, M.; Mehran, M.; Yazdi, M.H.; Haghgoo, R.; Alaeddini, M. The strategic role of biotics in dental caries prevention: A scoping review. Food Sci. Nutr. 2024, 12, 8651–8674. [Google Scholar] [CrossRef]
- Saggar, S.; Mir, P.A.; Kumar, N.; Chawla, A.; Uppal, J.; Kaur, A. Traditional and herbal medicines: Opportunities and challenges. Pharmacogn. Res. 2022, 14, 107–114. [Google Scholar]
- Wachtel-Galor, S.; Benzie, I.F.F. Herbal Medicine: Biomolecular and Clinical Aspects, 2nd ed.; CRC Press: Boca Raton, FL, USA, 2011. [Google Scholar]
- Petersen, P.E. World Health Organization global policy for improvement of oral health—World Health Assembly 2007. Int. Dent. J. 2008, 58, 115–121. [Google Scholar] [CrossRef]
- Budala, D.G.; Martu, M.-A.; Maftei, G.-A.; Diaconu-Popa, D.A.; Danila, V.; Luchian, I. The role of natural compounds in optimizing contemporary dental treatment—Current status and future trends. J. Funct. Biomater. 2023, 14, 273. [Google Scholar] [CrossRef]
- Sakagami, H.; Tomomura, M. Dental application of natural products. Medicines 2018, 5, 21. [Google Scholar] [CrossRef]
- Groppo, F.C.; Bergamaschi, C.d.C.; Cogo, K.; Franz-Montan, M.; Motta, R.H.L.; Andrade, E.D.d. Use of phytotherapy in dentistry. Phytother. Res. 2008, 22, 993–998. [Google Scholar] [CrossRef]
- Sorrenti, V.; Burò, I.; Consoli, V.; Vanella, L. Recent advances in health benefits of bioactive compounds from food wastes and by-products: Biochemical aspects. Int. J. Mol. Sci. 2023, 24, 2019. [Google Scholar] [CrossRef]
- Senthilkumar, K.; Venkateswaran, S.; Vasanthan, A.; Chiranjeevi, P.; Mohamed, N.; Dinesh, S.; Neshkumar, K. Formulation development and evaluation of novel herbal toothpaste from natural source. Int. J. Pharm. Chem. Anal. 2022, 9, 17–21. [Google Scholar] [CrossRef]
- COSMOS Standard Criteria, Cosmetics Organic and Natural Standard; Cosmos Standard Criteria: Brussels, Belgium, 2013.
- Ferreira, M.; Matos, A.; Couras, A.; Marto, J.; Ribeiro, H. Overview of cosmetic regulatory frameworks around the world. Cosmetics 2022, 9, 72. [Google Scholar] [CrossRef]
- Dospra, M.; Pavlou, P.; Varvaresou, A.; Papageorgiou, S. Papain: A promising enzyme with bactericidal, anti-inflammatory action for dermal and dental applications. Pharmakeftiki 2024, 36, 3. [Google Scholar]
- Chen, X.; Daliri, E.B.-M.; Kim, N.; Kim, J.-R.; Yoo, D.; Oh, D.-H. Microbial Etiology and Prevention of Dental Caries: Exploiting Natural Products to Inhibit Cariogenic Biofilms. Pathogens 2020, 9, 569. [Google Scholar] [CrossRef] [PubMed]
- Dionysopoulos, D.; Papageorgiou, S.; Malletzidou, L.; Gerasimidou, O.; Tolidis, K. Effect of Novel Charcoal-Containing Whitening Toothpaste and Mouthwash on Color Change and Surface Morphology of Enamel. J. Conserv. Dent. 2020, 23, 624–631. [Google Scholar] [CrossRef]
- Dionysopoulos, D.; Papageorgiou, S.; Papadopoulos, C.; Davidopoulou, S.; Konstantinidis, A.; Tolidis, K. Effect of Whitening Toothpastes with Different Active Agents on the Abrasive Wear of Dentin Following Tooth Brushing Simulation. J. Funct. Biomater. 2023, 14, 268. [Google Scholar] [CrossRef] [PubMed]
- Epasinghe, D.; Yiu, C.; Burrow, M. Effect of Flavonoids on Remineralization of Artificial Root Caries. Aust. Dent. J. 2016, 61, 196–202. [Google Scholar] [CrossRef]
- Isola, G. Current Evidence of Natural Agents in Oral and Periodontal Health. Nutrients 2020, 12, 585. [Google Scholar] [CrossRef]
- Dubey, S. Comparative Antimicrobial Efficacy of Herbal Alternatives (Emblica officinalis, Psidium guajava), MTAD, and 2.5% Sodium Hypochlorite Against Enterococcus faecalis: An In Vitro Study. J. Oral Biol. Craniofac. Res. 2016, 6, 46–49. [Google Scholar] [CrossRef]
- Papageorgiou, S.; Varvaresou, A.; Tsirivas, E.; Demetzos, C. New Alternatives to Cosmetics Preservation. J. Cosmet. Sci. 2010, 61, 107–123. [Google Scholar]
- Okawa, M.; Kinjo, J.; Nohara, T.; Ono, M. DPPH (1,1-Diphenyl-2-Picrylhydrazyl) Radical Scavenging Activity of Flavonoids Obtained from Some Medicinal Plants. Biol. Pharm. Bull. 2001, 24, 1202–1205. [Google Scholar] [CrossRef] [PubMed]
- Tlili, N.; Elfalleh, W.; Hannachi, H.; Yahia, Y.; Khaldi, A.; Ferchichi, A.; Nasri, N. Screening of Natural Antioxidants from Selected Medicinal Plants. Int. J. Food Prop. 2013, 16, 1117–1126. [Google Scholar] [CrossRef]
- Alizadeh Behbahani, B.; Imani Fooladi, A.A. Evaluation of Phytochemical Analysis and Antimicrobial Activities of Allium Essential Oil Against the Growth of Some Microbial Pathogens. Microb. Pathog. 2018, 114, 299–303. [Google Scholar] [CrossRef] [PubMed]
- Wang, Q.; Wang, H.; Xie, M. Antibacterial Mechanism of Soybean Isoflavone on Staphylococcus aureus. Arch. Microbiol. 2010, 192, 893–898. [Google Scholar] [CrossRef]
- Pasupuleti, M.K.; Nagate, R.R.; Alqahtani, S.M.; Penmetsa, G.S.; Gottumukkala, S.N.V.S.; Ramesh, K.S.V. Role of medicinal herbs in periodontal therapy: A systematic review. J. Int. Soc. Prev. Community Dent. 2023, 13, 9–16. [Google Scholar] [CrossRef]
- Ahmed, O.A.K.; Sibuyi, N.R.S.; Fadaka, A.O.; Maboza, E.; Olivier, A.; Madiehe, A.M.; Meyer, M.; Geerts, G. Prospects of using gum arabic silver nanoparticles in toothpaste to prevent dental caries. Pharmaceutics 2023, 15, 871. [Google Scholar] [CrossRef]
- Philip, N.; Leishman, S.J.; Bandara, H.M.H.N.; Healey, D.L.; Walsh, L.J. Randomized Controlled Study to Evaluate Microbial Ecological Effects of CPP-ACP and cranberry on dental plaque. JDR Clin. Trans. Res. 2020, 5, 118–126. [Google Scholar] [CrossRef]
- EC 1223/2009; Regulation (EC) No 1223/2009 of the European Parliament and of the Council of 30 November 2009 on Cosmetic Products. Official Journal of the European Union: Luxembourg, 2009. Available online: https://eur-lex.europa.eu/eli/reg/2009/1223/oj/eng/pdf (accessed on 18 February 2025).
- Dini, I.; Laneri, S. The new challenge of green cosmetics: Natural food ingredients for cosmetic formulations. Molecules 2021, 26, 3921. [Google Scholar] [CrossRef]
- Tendencia, E.A. Laboratory Manual of Standardized Methods for Antimicrobial Sensitivity Tests for Bacteria Isolated from Aquatic Animals and Environment; Southeast Asian Fisheries Development Center: Bangkok, Thailand, 2004. [Google Scholar]
- De Camargo Smolarek, P.; Esmerino, L.A.; Chibinski, A.C.; Bortoluzzi, M.C.; dos Santos, E.B.; Kozlowski, V.A. In vitro antimicrobial evaluation of toothpastes with natural compounds. Eur. J. Dent. 2015, 9, 580–586. [Google Scholar] [CrossRef]
- Marinho, V.T.; dos Reis, A.C.; da Costa Valente, M.L. Efficacy of antimicrobial agents in dentifrices: A systematic review. Antibiotics 2022, 11, 1413. [Google Scholar] [CrossRef]
- Cai, Q.; Xian, P.; Shaotang, Y.; Miaomiao, Z.; Xin, X.; Xingqun, C. Evaluation of the antibacterial and anti-inflammatory effects of a natural products-containing toothpaste. Front. Cell. Infect. Microbiol. 2022, 12, 827643. [Google Scholar] [CrossRef]
- Cazarolli, L.H.; Zanatta, L.; Alberton, E.H.; Figueiredo, M.S.R.B.; Folador, P.; Damazio, R.G.; Pizzolatti, M.G.; Barreto Silva, F.R.M. Mini Reviews in Medicinal Chemistry. Med. Chem. 2008, 8, 1429–1440. [Google Scholar]
- Fernandes, G.V.O.; Mosley, G.A.; Ross, W.; Dagher, A.; Martins, B.G.D.S.; Fernandes, J.C.H. Revisiting Socransky’s complexes: A review suggesting updated new bacterial clusters (GF-MoR complexes) for periodontal and peri-implant diseases and conditions. Microorganisms 2024, 12, 2214. [Google Scholar] [CrossRef] [PubMed]
- Kumar, M.; Prakash, S.; Radha; Kumari, N.; Pundir, A.; Punia, S.; Saurabh, V.; Choudhary, P.; Changan, S.; Dhumal, S.; et al. Beneficial Role of Antioxidant Secondary Metabolites from Medicinal Plants in Maintaining Oral Health. Antioxidants 2021, 10, 1061. [Google Scholar] [CrossRef]
- Pietta, P.-G. Flavonoids as Antioxidants. Nat. Prod. Rep. 2000, 63, 1035–1042. [Google Scholar] [CrossRef]
- Abdolahinia, E.D.; Hajisadeghi, S.; Moayedi Banan, Z.; Dadgar, E.; Delaramifar, A.; Izadian, S.; Sharifi, S.; Dizaj, S.M. Potential Applications of Medicinal Herbs and Phytochemicals in Oral and Dental Health: Status Quo and Future Perspectives. Oral Dis. 2023, 29, 2468–2482. [Google Scholar] [CrossRef]
- García-Contreras, R.; Argueta-Figueroa, L.; Mejía-Rubalcava, C.; Jiménez-Martínez, R.; Cuevas-Guajardo, S.; Sánchez-Reyna, P.A.; Mendieta-Zeron, H. Perspectives for the Use of Silver Nanoparticles in Dental Practice. Int. Dent. J. 2011, 61, 297–301. [Google Scholar] [CrossRef]
- Yin, I.X.; Zhang, J.; Zhao, I.S.; Mei, M.L.; Li, Q.; Chu, C.H. The Antibacterial Mechanism of Silver Nanoparticles and Its Application in Dentistry. Int. J. Nanomed. 2020, 15, 2555–2562. [Google Scholar] [CrossRef]
- Liao, C.; Li, Y.; Tjong, S.C. Bactericidal and Cytotoxic Properties of Silver Nanoparticles. Int. J. Mol. Sci. 2019, 20, 449. [Google Scholar] [CrossRef]
- Noronha, V.T.; Paula, A.J.; Durán, G.; Galembeck, A.; Cogo-Müller, K.; Franz-Montan, M.; Durán, N. Silver Nanoparticles in Dentistry. Dent. Mater. 2017, 33, 1110–1126. [Google Scholar] [CrossRef]
- Shigli, K.; Nayak, S.S.; Bolmal, U.B.; Shah, K. Cranberry and Oral Health. In Pharmacological Studies in Natural Oral Care; Chauhan, D.N., Singh, P.R., Chauhan, N.S., Shah, K., Eds.; Wiley: Hoboken, NJ, USA, 2023. [Google Scholar] [CrossRef]
- Feldman, M.; Tanabe, S.; Howell, A.; Grenier, D. Cranberry Proanthocyanidins Inhibit the Adherence Properties of Candida albicans and Cytokine Secretion by Oral Epithelial Cells. BMC Complement. Altern. Med. 2012, 12, 6. [Google Scholar] [CrossRef]
- Vinueza, M.E.G.; Dohle, E.; Obreja, K.; Sader, R.; Ramanauskaite, A.; Sarah, A.; Ghanaati, S.; Magini, R.; Schwarz, F. Anti-Inflammatory and Macrophage Polarization Effects of Cranberry Proanthocyanidins (PACs) for Periodontal and Peri-Implant Disease Therapy. J. Periodont. Res. 2020, 55, 821–829. [Google Scholar] [CrossRef]
- Kurauchi, M.; Niwano, Y.; Shirato, M.; Kanno, T.; Nakamura, K.; Egusa, H.; Sasaki, K. Cytoprotective Effect of Short-Term Pretreatment with Proanthocyanidin on Human Gingival Fibroblasts Exposed to Harsh Environmental Conditions. PLoS ONE 2014, 9, e113403. [Google Scholar] [CrossRef]
- Xu, Z.; Du, P.; Meiser, P.; Jacob, C. Proanthocyanidins: Oligomeric Structures with Unique Biochemical Properties and Great Therapeutic Promise. Nat. Prod. Commun. 2012, 7, 307–318. [Google Scholar] [CrossRef]
- Cahuana-Vasquez, R.A.; Cury, J.A. S. mutans Biofilm Model to Evaluate Antimicrobial Substances and Enamel Demineralization. Braz. Oral Res. 2010, 24, 135–141. [Google Scholar] [CrossRef]
- Palmer, S.R.; Ren, Z.; Hwang, G.; Liu, Y.; Combs, A.; Söderström, B.; Lara Vasquez, P.; Khosravi, Y.; Brady, L.J.; Koo, H.; et al. Streptococcus mutans yidC1 and yidC2 Impact Cell Envelope Biogenesis, the Biofilm Matrix, and Biofilm Biophysical Properties. J. Bacteriol. 2019, 201, e00396-18. [Google Scholar] [CrossRef] [PubMed]
- Zhang, Q.; Nijampatnam, B.; Hua, Z.; Nguyen, T.; Zou, J.; Cai, X.; Michalek, S.M.; Velu, S.E.; Wu, H. Structure-Based Discovery of Small Molecule Inhibitors of Cariogenic Virulence. Sci. Rep. 2017, 7, 5974. [Google Scholar] [CrossRef]
- Colombo, A.V.; Silva, C.M.; Haffajee, A.; Colombo, A.P.V. Identification of Oral Bacteria Associated with Crevicular Epithelial Cells from Chronic Periodontitis Lesions. J. Med. Microbiol. 2006, 55, 609–615. [Google Scholar] [CrossRef]
- Leung, K.-P.; Subramaniam, P.S.; Okamoto, M.; Fukushima, H.; Lai, C.-H. The Binding and Utilization of Hemoglobin by Prevotella intermedia. FEMS Microbiol. Lett. 1998, 162, 227–233. [Google Scholar] [CrossRef][Green Version]
- Cekici, A.; Kantarci, A.; Hasturk, H.; Van Dyke, T.E. Inflammatory and Immune Pathways in the Pathogenesis of Periodontal Disease. Periodontol. 2000 2014, 64, 57–80. [Google Scholar] [CrossRef]
- Cavalheiro, M.; Teixeira, M.C. Candida Biofilms: Threats, Challenges, and Promising Strategies. Front. Med. 2018, 5, 28. [Google Scholar] [CrossRef]
- Sardi, J.C.O.; Scorzoni, L.; Bernardi, T.; Fusco-Almeida, A.M.; Mendes Giannini, M.J.S. Candida Species: Current Epidemiology, Pathogenicity, Biofilm Formation, Natural Antifungal Products, and New Therapeutic Options. J. Med. Microbiol. 2013, 62, 10–24. [Google Scholar] [CrossRef] [PubMed]

| Ingredients | Commercial Name | INCI Name | % (w/w) |
|---|---|---|---|
| Deionized water | - | Aqua | 11.78 |
| Purox S | Emerald Chemical | Sodium Benzonate | 0.40 |
| Sodium fluoride powder | Honeywell | Sodium Fluoride | 0.32 |
| Meritol 160 | TereosSyral | Sorbitol | 60.00 |
| Xivia C | Danisco | Xylitol | 5.00 |
| Blanose 7M1F | Ashland | Sodium Carboxymethylcellulose | 1.50 |
| Tixosil 73 | Solvay | Hydrated Silica | 8.00 |
| Tixosil 43 | Solvay | Hydrated Silica | 9.00 |
| Medialan LD PF10 | Clariant | Aqua, Sodium LauroylSarcosinate | 3.00 |
| Flavor Natural Strong Mint | Vioryl | Aroma | 1.00 |
| Commercial Name of the Natural Antimicrobial Agent (Manufacturer) | INCI Name—Composition | Content (% w/w) | Physical Characteristics of the Natural Antimicrobial Agent |
|---|---|---|---|
| Biosecur Organic Oral Care (Sharon) | Glycerin, Citrus Reticulata Fruit Extract, Citrus Aurantium Amara Fruit Extract, Citrus Aurantium Sinensis Peel Extract, Ascorbic Acid, Citric Acid, Lactic Acid, Water | 0.1% | Brown, slightly viscous liquid consisting of a mixture of citrus extracts in glycerin (extracts from: mandarin fruit, bitter orange fruit, sweet orange peel) |
| Microsilver BG (BioGate) | Silver | 0.1% | Grey powder |
| Cranberry LG (Givaudan) | Glycerin, Vaccinium Macrocarpon Extract, Water | 0.5% | Colorless solution of cranberry extract in glycerin |
| Antimicrobial Natural Toothpaste | Appearance/Color | Flavor/Odor | pH | Viscosity (Brookfirld DVI+, Spindle: F−96, rpm: 1.5, T: 20 °C) |
|---|---|---|---|---|
| Biosecur Organic Oral Care (0.1% w/w) | Yellowish gel | Characteristic of flavor (mint) | 6.89 | 313.000 cPs |
| Microsilver BG (0.1% w/w) | Grey gel | Characteristic of flavor (mint) | 6.85 | 289.000 cPs |
| Cranberry LG (0.5% w/w) | Transparent gel | Characteristic of flavor (mint) | 6.78 | 285.000 cPs |
| Name (Lot Number) | Characteristics | Incubation Conditions | Nutrient Ingredients |
|---|---|---|---|
| Candida albicans (ATCC 10231) | Fungus, one of the main microorganisms of the normal oral flora, which, however, can grow, multiply easily, and cause fungal infections in the oral cavity | 2 days at 25 °C | Sabouraud Dextrose Agar |
| Streptococcus mutans (ATCC 25175) | Gram-positive, anaerobic, round bacterium (coccus), commonly found in the human oral cavity and significantly contributes to the formation of dental caries | 2 days at 37 °C | Brain Heart Infusion Agar |
| Prevotella intermedia (ATCC 25611) | Gram-negative, anaerobic pathogenic bacterium involved in periodontal infections such as gingivitis and periodontitis | 2 days at 37 °C | Soybean-Casein Digest Agar |
| Microorganism | Toothpaste Sample A (mm) | Toothpaste Sample B (mm) | Toothpaste Sample C (mm) | Control- Sample D (mm) | Control+ Sample E (mm) | Sterilized Water (Negative Test) (mm) |
|---|---|---|---|---|---|---|
| Candida albicans | 20.0 ± 1.0 A | 19.3 ± 1.2 A | 18.7 ± 1.5 A | 14.3 ± 2.3 B | 22.3 ± 2.1 C | 0.0 ± 0.0 D |
| Streptococcus mutans | 97.7 ± 17.0 A | 70.3 ± 3.1 B | 69.7 ± 4.5 B | 74.3 ± 14.6 B | 81.0 ± 13.1 C | 0.0 ± 0.0 D |
| Prevotella intermedius | 59.7 ± 1.2 A | 53.0 ± 8.9 B | 57.0 ± 3.6 A | 52.0 ± 1.7 B | 52.7 ± 7.6 B | 0.0 ± 0.0 C |
Disclaimer/Publisher’s Note: The statements, opinions and data contained in all publications are solely those of the individual author(s) and contributor(s) and not of MDPI and/or the editor(s). MDPI and/or the editor(s) disclaim responsibility for any injury to people or property resulting from any ideas, methods, instructions or products referred to in the content. |
© 2025 by the authors. Licensee MDPI, Basel, Switzerland. This article is an open access article distributed under the terms and conditions of the Creative Commons Attribution (CC BY) license (https://creativecommons.org/licenses/by/4.0/).
Share and Cite
Papageorgiou, S.; Tsouna, A.; Pavlou, P.; Varvaresou, A.; Papadopoulos, A.; Davidopoulou, S.; Dionysopoulos, D.; Giannakoudaki, A. In Vitro Evaluation of the Antimicrobial Properties of Natural Toothpastes Containing Silver, Citrus, and Cranberry Extracts Against Oral Pathogenic Microorganisms. Appl. Sci. 2025, 15, 3704. https://doi.org/10.3390/app15073704
Papageorgiou S, Tsouna A, Pavlou P, Varvaresou A, Papadopoulos A, Davidopoulou S, Dionysopoulos D, Giannakoudaki A. In Vitro Evaluation of the Antimicrobial Properties of Natural Toothpastes Containing Silver, Citrus, and Cranberry Extracts Against Oral Pathogenic Microorganisms. Applied Sciences. 2025; 15(7):3704. https://doi.org/10.3390/app15073704
Chicago/Turabian StylePapageorgiou, Spyros, Angeliki Tsouna, Panagoula Pavlou, Athanasia Varvaresou, Apostolos Papadopoulos, Sotiria Davidopoulou, Dimitrios Dionysopoulos, and Anna Giannakoudaki. 2025. "In Vitro Evaluation of the Antimicrobial Properties of Natural Toothpastes Containing Silver, Citrus, and Cranberry Extracts Against Oral Pathogenic Microorganisms" Applied Sciences 15, no. 7: 3704. https://doi.org/10.3390/app15073704
APA StylePapageorgiou, S., Tsouna, A., Pavlou, P., Varvaresou, A., Papadopoulos, A., Davidopoulou, S., Dionysopoulos, D., & Giannakoudaki, A. (2025). In Vitro Evaluation of the Antimicrobial Properties of Natural Toothpastes Containing Silver, Citrus, and Cranberry Extracts Against Oral Pathogenic Microorganisms. Applied Sciences, 15(7), 3704. https://doi.org/10.3390/app15073704

